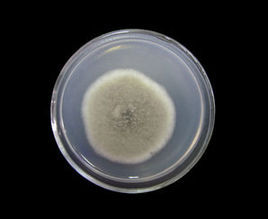
微生物馴化 微生物馴化

馴化方法
天然馴化
比如在某污染地點附近(酸,鹽鹼或者重金屬),在他周圍本來微生物是多種多樣的,但是隨著污染物的對微生物的生長抑制和毒害作用,大部分的被抑制生長或者殺死,只有部分能適應或者產生變異的微生物留下來,成為優勢菌群,這就是天然馴化。
人工馴化
就是在培養過程中,逐步加入某種物質,讓細菌循序漸進的適應這個繁殖環境,從而馴化出對此種物質耐受或者能降解的微生物群體和種類。
套用領域
一般套用於環保行業,醫藥發酵行業,食品發酵行業等。
微生物馴化就是馴化微生物的行為。在細菌培養基中循序漸進的加入靶向環境的材料或基質,讓細菌逐漸適應並依賴靶向環境的材料或基質,從而達到改善或改變環境中的有效成分。
比如在某污染地點附近(酸,鹽鹼或者重金屬),在他周圍本來微生物是多種多樣的,但是隨著污染物的對微生物的生長抑制和毒害作用,大部分的被抑制生長或者殺死,只有部分能適應或者產生變異的微生物留下來,成為優勢菌群,這就是天然馴化。
就是在培養過程中,逐步加入某種物質,讓細菌循序漸進的適應這個繁殖環境,從而馴化出對此種物質耐受或者能降解的微生物群體和種類。
一般套用於環保行業,醫藥發酵行業,食品發酵行業等。
